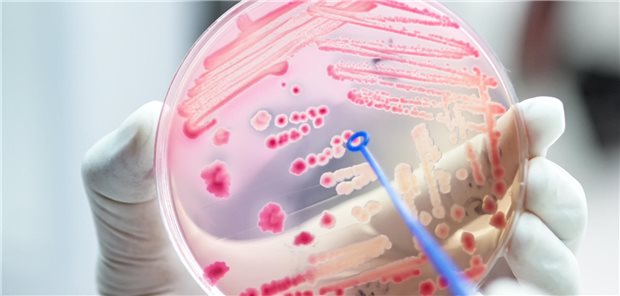
So lassen sich Antibiotika-Verordnungen im Praxisalltag reduzieren Bakterienkultur in Petrischale

Mittelgradiges bis schweres Asthma bronchiale
Bessere Kontrolle und Lebensqualität unter inhalativer Triple-Therapie
Bei der Asthmatherapie gibt es seit einigen Jahren ein Umdenken. Statt als Reaktion auf Symptome die Therapie stufenweise zu eskalieren, wird auf den dauerhaften Einsatz präventiv wirkender Medikamente gesetzt [1, 2]. Das Ziel ist eine möglichst langfristige Asthmakontrolle, im Idealfall Remission bei wenig Nebenwirkungen. Eine Triple-Therapie aus inhalativem Kortikosteroid (ICS), langwirksamem Betamimetikum (LABA) und langwirksamem Anticholinergikum (LAMA) ist ein wichtiger Baustein der neuen Strategie. Neue Daten, vorgestellt bei der Jahrestagung 2025 der European Respiratory Society (ERS) in Amsterdam, Niederlande, belegen dies für die extrafeine Dreifachfixkombination Beclometasondipropionat, Formoterolfumarat, Glycopyrronium (BDP/FF/GB).